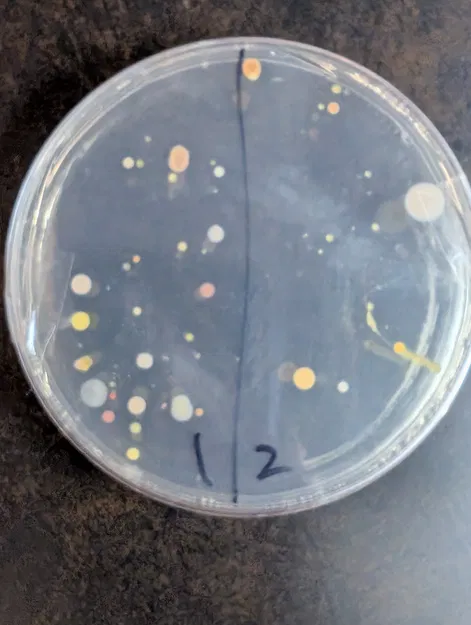
Tops Our Fun - Image 1

Tops Our Fun
Mẫu 3D “tops our fun” với mô tả ngắn gọn là “top”. Nội dung hiện tại khá tối giản, phù hợp để bạn bổ sung thêm thông tin như kích thước, vật liệu in (PLA/PETG), thông số layer height và mục đích sử dụng.
30
Lượt Xem
0
Lượt Thích
0
Lượt Tải
Cập Nhật Feb 09, 2026

Chưa có bình luận nào. Hãy là người đầu tiên!